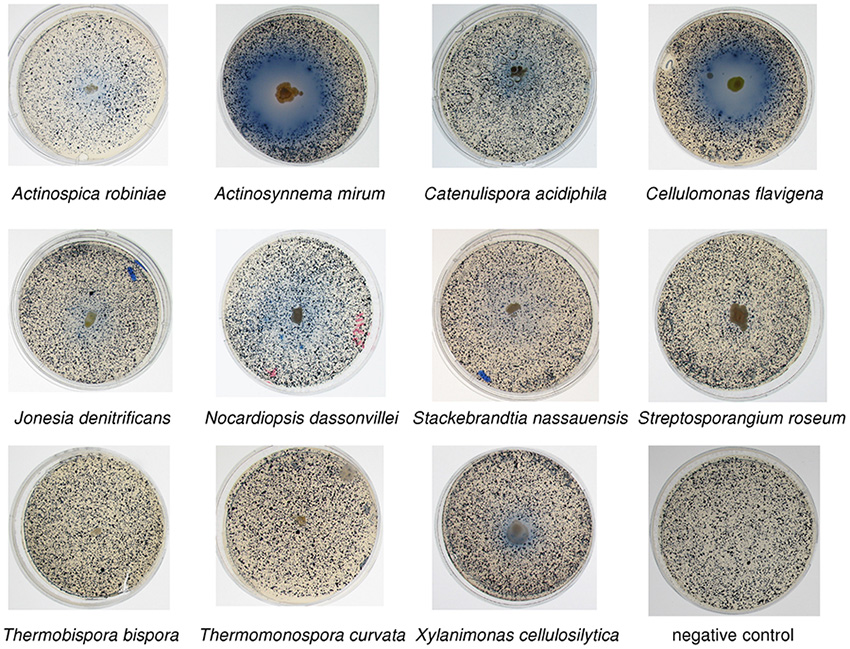

Underground Storage of Carbon Dioxide—as a Solid
Nanoscale features in rocks enable more carbon dioxide to be trapped as a solid carbonate material underground.

Nanoscale features in rocks enable more carbon dioxide to be trapped as a solid carbonate material underground.

Understanding how two microbes work together to produce the greenhouse gas methane.
A microbe not known for cellulose degradation has 15 cellulases that may improve biofuel production.

Insights into the origin of ligninases can help develop processes to convert biomass into bioenergy.

Impacts of anthropogenic warming on tropical land region rainfall.

Enzymes originating from marine sponges were intentionally altered to create a new enzyme that can make semiconductors in artificial cells.

House-of-Cards structure leads to improved zeolite catalyst.

Chemistry provides a route to selective binding and extraction of radioactive cesium.

Researchers use NERSC to Create Carbon Dioxide-Separating Polymer.

New calculations have quantified the boundaries and uncertainties of the ‘chart of the nuclides’—the extended periodic table of all matter.

Imaging tools aid research in global climate change, plant genetics, biofuels, agriculture, and carbon sequestration.

A polar alga with lipid metabolism enzymes may prove useful harnessing algae for biodiesel production.